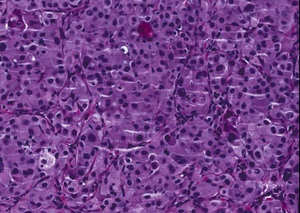

PDX LIVE™:根据需求开展的药效研究
表型明确的临床相关模型。
快速的研究启动和经过优化的研究设计。
数据测量时间以周为单位,而不是以月为单位。
快速的研究启动和经过优化的研究设计。
数据测量时间以周为单位,而不是以月为单位。
jax-orderquest@ibio-life.com | 400-693-5700 (询价下单/技术咨询)

| 主要部位 | 模型编号 | 又名 |
|---|---|---|
| 膀胱 | TM00016 | BL0293 |
| 乳腺 | TM00098 | BR1126F |
| TM00089 | BR0620F | |
| TM00386 | BR0555F | |
| TM00096 | BR0851F | |
结肠 | TM00170 | CN1572F |
肺 | TM00302 | LG1306aF |
| TM00219 | LG1049F | |
| TM00233 | LG1202 | |
| TM00199 | LG0703F | |
| 卵巢 | TM00335 | OV1828F |
| 胰腺 | TM01212 | TM01212F |
| 前列腺 | TM00298 | PR1996F |
| 皮肤 | J000106560 | PS4050 |
| 研究类型 | 分组 | 溶媒 | 标准治疗 (standard-of-care, SOC) | 药物 A | 药物 B | 药物 A + B 联合用药 |
|---|---|---|---|---|---|---|
| 1. 药效研究预实验 | 3 | 1 | 1 | 1 | 0 | 0 |
| 2. 剂量反应 | 5 | 1 | 1 | 3 | 0 | 0 |
| 3. 联合用药 | 4 | 1 | 0 | 1 | 1 | 1 |
| 4. 耐受性 | 3 | 1 | 0 | 2 | 0 | 0 |



 3B.
3B. 3C.
3C.

5A. 5B.
5B. 